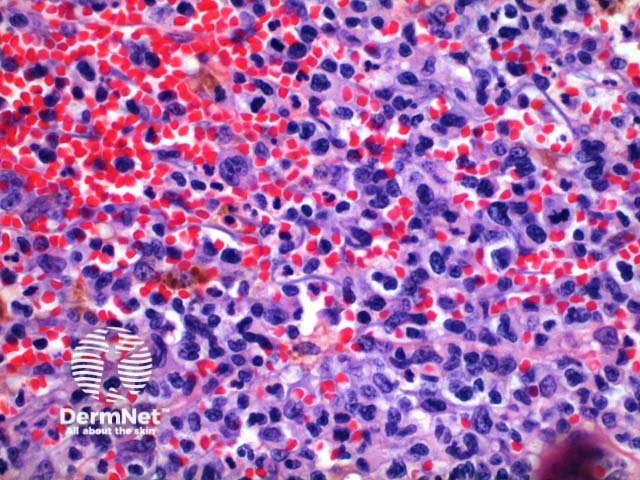
Figure 5

Main menu
Common skin conditions
NEWS
Join DermNet PRO
Read more
Quick links
Lesions (cancerous) Systemic diseases Diagnosis and testing
Author: Dr Ben Tallon, Dermatologist/Dermatopathologist, Tauranga, New Zealand, 2011. Updated: Dr Ben Tallon, May 2021
Lymphomatoid papulosis is one of the two primary cutaneous CD30-positive cutaneous lymphoproliferative disorders, as classified by the WHO/EORTC. Six histological types have been described.
Scanning power of the pathology of lymphomatoid papulosis reveals a wedge-shaped inflammatory infiltrate extending to the deep dermis or superficial subcutaneous tissue (Figures 1 and 2). Note, it is made of prominent telangiectatic vessels and extravasation of erythrocytes in the case illustrated here (Figures 3 and 4). The lymphocytic population is comprised of a number of large CD30-positive lymphocytes (Figure 5). The mixture of cells forms a spectrum.
Type A: Scattered or grouped large CD30-positive lymphocytes (Figure 6) in a background of eosinophils and neutrophils.
Type B: A population of small lymphocytes may be seen with epidermotropism. This type may resemble mycosis fungoides.
Type C: Sheets of large anaplastic cells with only few admixed inflammatory cells resembling anaplastic large cell lymphoma.
Type D: Marked epidermotropism is seen histologically indistinguishable from primary cutaneous aggressive epidermotropic CD8+ cytotoxic T cell lymphoma.
Type E: Angiocentric infiltrate of small and medium sized lymphocytes. CD8+ > CD4+ infiltrate on immunostaining.
6p25.3 rearrangement: Epidermotropic population of small CD30+ cells, with medium and large pleomorphic dermal lymphocytes.

Figure 1

Figure 2

Figure 3

Figure 4
Figure 5

Figure 6
A panel of immunoperoxidase markers is used, the key finding is CD30 positivity in Types A and C. Typically the tumour cells are CD4+, but CD8+ and CD56+ variants have been described. TIA-1, perforin, and granzyme-B is expressed while ALK-1 is negative.
Fascin expression may indicate an increased risk for secondary malignancies.
Primary cutaneous anaplastic large cell lymphoma: This tumour presents clinically as typically a large solitary ulcerated tumour. Strictly by definition >75% of the tumour cells must stain CD30 positive. A large nodular and cohesive population of large anaplastic cells is seen. Type C lymphomatoid papulosis bears the closest resemblance to this entity.
Pseudolymphomatous drug eruption and arthropod bites present with scattered CD30+ lymphocytes, largely not forming clusters or sheets. There is a mixed plasma cell and B-cell population.